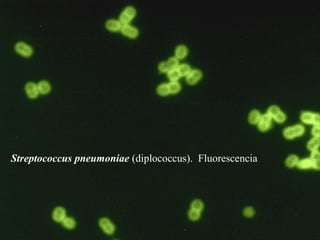
Streptococcus pneumoniae (diplococcus). Fluorescencia
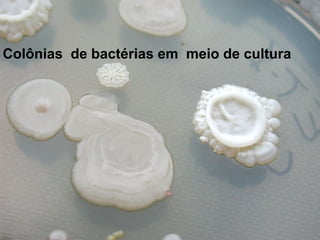
Colônias de bactérias em meio de cultura

O documento resume as principais características das bactérias, incluindo sua estrutura celular, métodos de reprodução, formas de resistência e importância ecológica. Aborda os tipos de bactérias, como procariotos, e detalha a estrutura da célula bacteriana, incluindo membrana, parede celular, flagelos e plasmídeos. Também descreve os métodos de reprodução como conjugação, transdução e transformação, além das formas de resistência como espores e troca de informação genética.